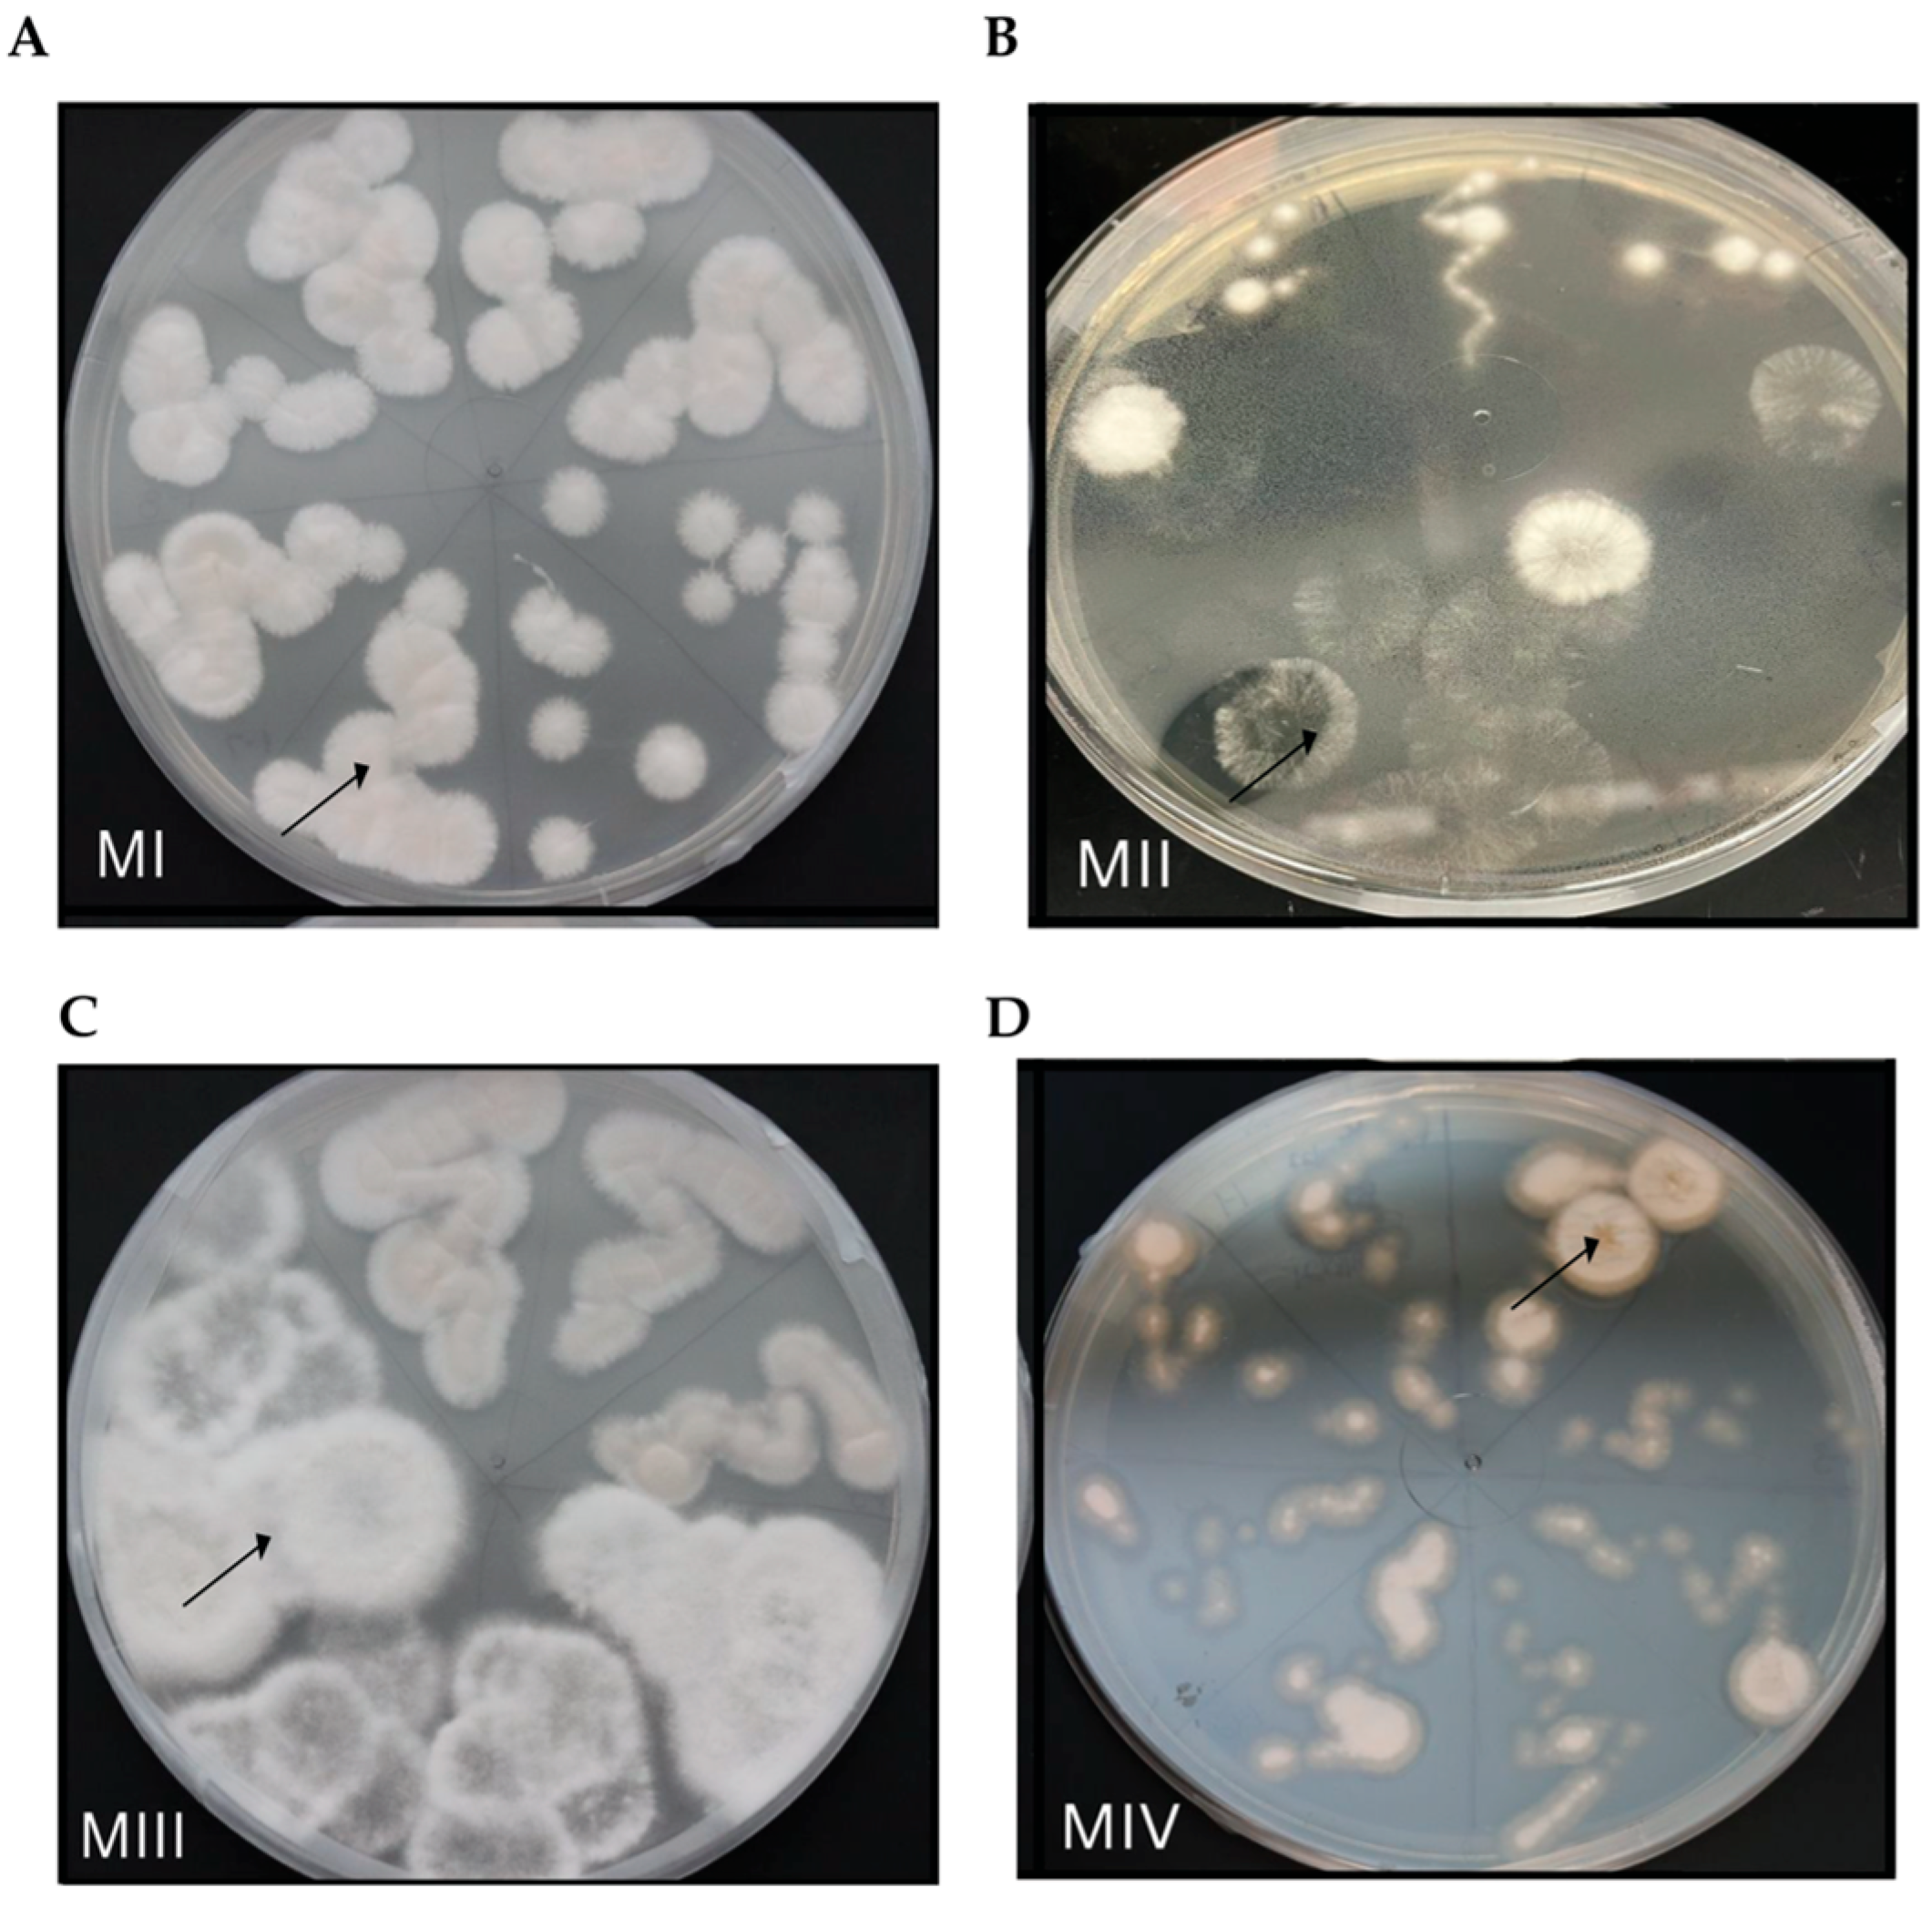
Microorganisms 13 02269 g004

It’s a Question at the ‘Root’ of the Problem: Fungal Associations of Dionaea muscipula (Venus’ Flytrap) Roots in Its Native Habitat
Abstract
1. Introduction
2. Materials and Methods
2.1. Collection of Roots and Soil
2.2. Microscopy
2.3. Fungal Cultures
2.4. Extraction and Amplification of Fungal DNA for Species Identification of Fungal Endophytes
2.5. Rhizosphere Soil Samples
3. Results
3.1. Microscopy of Trypan Blue Stained D. muscipula Root Tissues
3.2. Fungal Endophytes from D. muscipula Roots
3.3. Fungal Rhizosphere Surrounding Native Venus’ Flytrap Roots of South Carolina
4. Discussion
4.1. Native D. muscipula Roots Harbor Arbuscular Mycorrhizae
4.2. Fungal Endophytes of Native Venus’ Flytrap Roots
4.3. Soil Rhizome Surrounding Native D. muscipula Roots in South Carolina
5. Conclusions
Supplementary Materials
Author Contributions
Funding
Institutional Review Board Statement
Informed Consent Statement
Data Availability Statement
Acknowledgments
Conflicts of Interest
Abbreviations
| LOBHP | Lewis Ocean Bay Heritage Preserve |
| EC | Environmental Control |
| Pop1 | Population 1 |
| Pop2 | Population 2 |
| Pl. | Plant (A, B, C of each population) |
| PDA | Potato Dextrose Agar |
| AMF | Arbuscular mycorrhizal fungi |
| PEG | Polyethylene Glycol |
| OTU | Operational Taxonomic Unit |
References
- Roberts, P.R.; Oosting, H.J. Responses of Venus Fly Trap (Dionaea muscipula) to factors involved in its endemism. Ecol. Monogr. 1958, 28, 193–218. [Google Scholar] [CrossRef]
- Luken, J.O. Habitats of Dionaea muscipula (Venus’ Fly Trap) Droseraceae, associated with Carolina bays. Southeast. Nat. 2005, 4, 573–584. [Google Scholar] [CrossRef]
- Laliberte, L.; Luken, J.O.; Hutchens, J.J., Jr.; Godwin, K.S. The ecological boundaries of six Carolina bays: Community composition and ecotone distribution. Wetlands 2007, 27, 873–883. [Google Scholar] [CrossRef]
- Gray, J.B.; Wentworth, T.R.; Brownie, C. Extinction, colonization, and persistence of rare vascular flora in the longleaf pine-wiregrass ecosystem: Responses to fire frequency and population size. Nat. Areas J. 2003, 23, 210–219. [Google Scholar]
- SC SWAP. Chapter 2: South Carolina’s Priority Species (Species of Greatest Conservation Need). In South Carolina’s Priority Species SC; SC DNR: West Columbia, SC, USA, 2015. [Google Scholar]
- Garner, B. Successful Protection and Management Efforts Keep Venus Flytrap Off the Endangered Species List; U.S. Fish and Wildlife: Washington, DC, USA, 2023. [Google Scholar]
- Margulies, J.D.; Trost, B.; Hamon, L.; Kerr, N.Z.; Kunz, M.; Randall, J.L.; Shew, R.D.; Shew, D.M.; Starke, L.; Suiter, D.; et al. Expert assessment of illegal collecting impacts on Venus flytraps and priorities for research on illegal trade. Conserv. Biol. 2024, 38, e14320. [Google Scholar] [CrossRef]
- Luken, J.O. Long-term outcomes of Venus Flytrap (Dionaea muscipula) establishment. Restor. Ecol. 2012, 20, 669–670. [Google Scholar] [CrossRef]
- Hutchens, J.J., Jr.; Luken, J.O. Prey Capture Success by Established and Introduced Populations of the Venus Flytrap (Dionaea muscipula). Ecol. Restor. 2015, 33, 171–177. [Google Scholar] [CrossRef]
- Humphreys, C.P.; Franks, P.J.; Rees, M.; Bidartondo, M.I.; Leake, J.R.; Beerling, D.J. Mutualistic mycorrhiza-like symbiosis in the most ancient group of land plants. Nat. Commun. 2010, 1, 103. [Google Scholar] [CrossRef]
- Wu, Y.; Chen, C.; Wang, G. Inoculation with arbuscular mycorrhizal fungi improves plant biomass and nitrogen and phosphorus nutrients: A meta-analysis. BMC Plant Biol. 2024, 24, 960. [Google Scholar] [CrossRef]
- Bermúdez-Contreras, A.I.; Monroy-Guzmán, C.; Pérez-Lucas, L.; Escutia-Sánchez, J.A.; Olmo-Ruiz, M.D.; Truong, C. Mycorrhizal fungi associated with juniper and oak seedlings along a disturbance gradient in Central Mexico. Front. For. Glob. Change 2022, 5, 736664. [Google Scholar] [CrossRef]
- Leventis, G.; Tsiknia, M.; Feka, M.; Ladikou, E.V.; Papadakis, I.E.; Chatzipavlidis, I.; Papadopoulou, K.; Ehaliotis, C. Arbuscular mycorrhizal fungi enhance growth of tomato under normal and drought conditions, via different water regulation mechanisms. Rhizosphere 2021, 19, 100394. [Google Scholar] [CrossRef]
- Jiang, Q.; Li, Q.; Chen, Y.; Zhong, C.; Zhang, Y.; Chen, Z.; Pinyopusarerk, K.; Bush, D. Arbuscular mycorrhizal fungi enhanced growth of Magnoia macclurei (Dandy) Figlar Seedlings grown under glasshouse conditions. For. Sci. 2017, 63, 441–448. [Google Scholar]
- Cosme, M.; Fernádez, I.; Van der Heijden, M.G.G.; Pieterse, C.M.J. Non-mycorrhizal plants: The exceptions that prove the rule. Trends Plant Sci. 2018, 23, 577–587. [Google Scholar] [CrossRef] [PubMed]
- Chandrasekaran, M. Arbuscular mycorrhizal fungi mediated alleviation of drought stress via non-enzymatic antioxidants: A Meta-analysis. Plants 2022, 11, 2448. [Google Scholar] [CrossRef] [PubMed]
- Stratton, C.A.; Ray, S.; Bradley, B.A.; Kaye, J.P.; Ali, J.G.; Murrell, E.G. Nutrition vs. association: Plant defenses are altered by arbuscular mycorrhizal fungi association not by nutritional provisioning alone. BMC Plant Biol. 2022, 22, 400. [Google Scholar] [CrossRef]
- Kawahara, A.; An, G.-H.; Miyakawa, S.; Sonoda, J.; Ezawa, T. Nestedness in arbuscular mycorrhizal fungal communities along soil pH gradients in early primary succession: Acid-tolerant fungi are pH generalists. PLoS ONE 2016, 11, e0165035. [Google Scholar] [CrossRef]
- Fernádez, I.; Cosme, M.; Stringlis, I.A.; Yu, K.; de Jonge, R.; van Wees, S.M.; Pozo, M.J.; Pieterse, C.M.J.; van der Heijden, M.G.A. Molecular dialogue between arbuscular mycorrhizal fungi and the nonhost plant Arabidopsis thaliana switches from initial detection to antagonism. N. Phytol. 2019, 223, 867–881. [Google Scholar] [CrossRef]
- Adamec, L.; Pavlovič, A. Mineral nutrition of terrestrial carnivorous plants. In Carnivorous Plants: Physiology, Ecology, and Evolution; Aaron Ellison, L.A., Ed.; Oxford Academic: Oxford, UK, 2018; Chapter 17. [Google Scholar]
- Adamec, L. Leaf absorption of mineral nutrients in carnivorous plants stimulates root nutrient uptake. N. Phytol. 2002, 155, 89–100. [Google Scholar] [CrossRef] [PubMed]
- Adlassnig, W.; Peroutka, M.; Lambers, H.; Lichtscheidl, I.K. The roots of carnivorous plants. Plant Soil 2005, 274, 127–140. [Google Scholar] [CrossRef]
- Gao, P.; Loeffler, T.S.; Honsel, A.; Kruse, J.; Krol, E.; Scherzer, S.; Kreuzer, I.; Bemm, F.; Buegger, F.; Burzlaff, T.; et al. Integration of trap- and root-derived nitrogen nutrition of carnivorous Dionaea muscipula. N. Phytol. 2015, 205, 1320–1329. [Google Scholar] [CrossRef]
- Santiago, Y.; Darnowski, D.W. Mycorrhizal formation by various carnivorous plants. Carniv. Plant Newsl. 2012, 41, 4–7. [Google Scholar] [CrossRef]
- Gange, A.C.; Eschen, R.; Wearn, J.A.; Thawer, A.; Sutton, B.C. Differential effects of foliar endophytic fungi on insect herbivores attacking a herbaceous plant. Oecologia 2012, 168, 1023–1031. [Google Scholar] [CrossRef] [PubMed]
- Cosme, M.; Lu, J.; Erb, M.; Stout, M.J.; Franken, P.; Wurst, S. A fungal endophyte helps plants to tolerate root herbivory through changes in gibberellin and jasmonate signaling. N. Phytol. 2016, 211, 1065–1076. [Google Scholar] [CrossRef]
- Sui, L.; Lu, Y.; Zhou, L.; Li, N.; Li, Q.; Zhang, Z. Endophytic Beauveria bassiana promotes plant biomass growth and suppresses pathogen damage by directional recruitment. Front. Microbiol. 2023, 14, 1227269. [Google Scholar] [CrossRef] [PubMed]
- Rodriguez, R.J.; Henson, J.; Van Vokenburgh, E.; Hoy, M.; Wright, L.; Beckwith, F.; Kim, Y.-O.; Redman, R.S. Stress tolerance in plants via habitat-adapted symbiosis. ISME J. 2008, 2, 404–416. [Google Scholar] [CrossRef]
- Quilliam, R.S.; Jones, D.L. Fungal root endophytes of the carnivorous plant Drosera rotundifolia. Mycorrhiza 2010, 20, 341–348. [Google Scholar] [CrossRef]
- Naseem, F.; Kayang, H. Endophytic fungal diversity of endemic carnivorous plant Nepenthes khasians in Meghalaya, India. Stud. Fungi 2021, 6, 138–150. [Google Scholar] [CrossRef]
- Rueda-Almazán, J.E.; Hernández, V.M.; Alcalá-Martínez, J.R.; Fernández-Duque, A.; Ruiz-Aguilar, M.; Alcalá, R.E. Spatial and temporal differences in the community structure of endophytic fungi in the carnivorous plant Pinguicula moranensis (Lentibulariaceae). Fungal Ecol. 2021, 53, 101087. [Google Scholar] [CrossRef]
- Shaw, B.J.P.; Ryves, D.B.; Glanville, H.; Young, E.B.; Millett, J. Culturable endophytes from carnivorous plant traps in the UK: Commonality of endophyte species across host species and sites. Mycol. Prog. 2024, preprint (under review). [Google Scholar]
- Sun, P.-F.; Lu, M.R.; Liu, Y.-C.; Shaw, B.J.P.; Lin, C.-P.; Chen, H.-W.; Lin, Y.-F.; Hoh, D.Z.; Ke, H.-M.; Wang, I.-F.; et al. An acidophilic fungus promotes prey digestion in a carnivorous plant. Nat. Microbiol. 2024, 9, 2522–2537. [Google Scholar] [CrossRef]
- Hawkins, H.-J.; Cargill, R.I.M.; Nuland, M.E.V.; Hagen, S.C.; Field, K.J.; Sheldrake, M.; Soudzilovskaia, N.A.; Kiers, E.T. Mycorrhizal mycelium as a global carbon pool. Curr. Biol. 2023, 33, R560–R573. [Google Scholar] [CrossRef]
- Moukarzel, R.; Ridgway, H.J.; Guerin-Laguette, A.; Jones, E.E. An improved clearing and staining protocol for evaluation of arbuscular mycorrhizal colonisation in darkly pigmented woody roots. N. Z. Plant Prot. 2020, 73, 33–39. [Google Scholar]
- Morawetz, J.J. A clearing protocol for whole tissues: An example using haustoria of Orobanchaceae. Appl. Plant Sci. 2013, 1, 1200361. [Google Scholar] [CrossRef]
- Delaux, P.-M.; Varala, K.; Edger, P.P.; Coruzzi, G.M.; Pires, J.C.; Ané, J.-M. Comparative phylogenomics uncovers the impact of symbiotic associations on host genome evolution. PLoS Genet. 2014, 10, e1004487. [Google Scholar]
- Sané, A.K.; Diallo, B.; Kane, A.; Ngom, M.; Cissoko, M.; Sy, M.O. Response to inoculation with arbuscular mycorrhizal fungi of two tomato (Solanum lycopersicum L.) varieties subjected to water stress under semi-controlled conditions. Agric. Sci. 2022, 13, 790–819. [Google Scholar] [CrossRef]
- Toju, H.; Tanabe, A.S.; Yamamoto, S.; Sato, H. High-coverage ITS primers for the DNA-based identification of Ascomycetes and Basidiomycetes in environmental samples. PLoS ONE 2012, 7, e40863. [Google Scholar] [CrossRef] [PubMed]
- Lee, J.; Lee, S.; Young, J.P.W. Improved PCR primers for the detection and identification of arbuscular mycorrhizal fungi. FEMS Microbiol. Ecol. 2008, 65, 339–349. [Google Scholar] [CrossRef] [PubMed]
- Camacho, C.; Coulouris, G.; Avagyan, V.; Ma, N.; Papadopoulos, J.; Bealer, K.; Madden, T.L. BLAST+: Architecture and applications. BMC Bioinform. 2009, 10, 421. [Google Scholar] [CrossRef]
- Smith, S.E.; Read, D.J. Chapter 1: The symbionts forming arbuscular mycorrhizas. In Mycorrhizal Symbiosis, 3rd ed.; Smith, S.E., Read, D., Eds.; Academic Press: London, UK, 2008; pp. 13–41. [Google Scholar]
- Vilela, L.A.F.; Damásio, M.M. Chapter 41: Molecular and cellular changes of arbuscular mycorrhizal fungi-plant interaction in pesticide contamination. In Handbook of Bioremediation: Physiological, Molecular and Biotechnological Interventions; Hasanuzzaman, M., Prasad, M.N.V., Eds.; Academic Press: London, UK, 2020; pp. 649–656. [Google Scholar]
- Ziane, H.; Hamza, N.; Meddad-Hamza, A. Arbuscular mycorrhizal fungi and fertilization rates optimize tomato (Solanum lycopersicum L.) growth and yield in a Mediterranean agroecosystem. J. Saudi Soc. Agric. Sci. 2021, 20, 454–458. [Google Scholar] [CrossRef]
- Toghueo, R.M.K.; Boyom, F.F. Endophytic Penicillium species and their agricultural, biotechnological, and pharmaceutical applications. 3 Biotech 2020, 10, 107. [Google Scholar] [CrossRef]
- MacDougal, D.T. Symbiotic Saprophytism. Ann. Bot. 1899, 13, 1–47. [Google Scholar] [CrossRef]
- Venugopal, N.; Devi, K.R.; Rao, C.S. An interesting observation on the mycorrhizal symbiosis in the insectivorous plant, Drosera peltata Sm., in Meghalaya, North-East India. Carniv. Plant Newsl. 2007, 36, 9–13. [Google Scholar] [CrossRef]
- Harikumar, V.S. Are there arbuscular mycorrhizal associations in carnivorous plants Drosera burmanii and D. indica? Bot. Serbica 2013, 37, 13–19. [Google Scholar]
- Rahmawati, R.; Megawati, K.; Yusran, Y. Arbuscular mycorrhizal fungi status of Nepenthes spp. around Lore Lindu National Park, Central Sulawesi, Indonesia. For. Ideas 2023, 29, 94–108. [Google Scholar]
- Stošić, S.; Ristić, D.; Savković, Ž.; Grbić, M.L.; Vukojević, J.; Živković, S. Penicillium and Talaromyces Species as Postharvest Pathogens of Pear Fruit (Pyrus communis) in Serbia. Plant Dis. 2021, 105, 3510–3521. [Google Scholar] [CrossRef]
- Shah, S.H.; Shan, X.; Baig, S.; Zhao, H.; Ismail, B.; Shahzadi, I.; Majeed, Z.; Nawazish, S.; Siddique, M.; Baig, A. First identification of potato tuber rot caused by Penicillium solitum, its silver nanoparticles synthesis, characterization and use against harmful pathogens. Front. Plant Sci. 2023, 14, 1255480. [Google Scholar] [CrossRef]
- Wang, F.; Zhang, R.; Yuan, Z.; Chen, P. Biological prevention and control of pitaya fruit canker disease using endophytic fungi isolated from papaya. Arch. Microbiol. 2021, 203, 4033–4040. [Google Scholar] [CrossRef]
- Araújo, K.S.; Alves, J.L.; Pereira, O.L.; de Queiroz, M.V. Five new species of endophytic Penicillium from rubber trees in the Brazilian Amazon. Braz. J. Microbiol. 2024, 55, 3051–3074. [Google Scholar] [CrossRef]
- Pangging, M.; Nguyen, T.T.T.; Lee, H.B. Seven New Records of Penicillium Species Belonging to Section Lanata-Divaricata in Korea. Mycobiology 2021, 49, 363–375. [Google Scholar] [CrossRef]
- Diao, Y.-Z.; Chen, Q.; Jiang, X.-Z.; Houbraken, J.; Barbosa, R.N.; Cai, L.; Wu, W.-P. Penicillium section Lanata-divaricata from acidic soil. Cladistics 2018, 35, 514–549. [Google Scholar] [CrossRef]
- Tanapichatsakul, C.; Khruengsai, S.; Mongoot, S.; Pripdeevech, P. Productin of eugenol from fungal endophytes Neopestalotiopsis sp. and Diaporthe sp. isolated from Cinnamomum loureiroi leaves. PeerJ 2019, 7, e6427. [Google Scholar]
- Ávila-Hernández, J.G.; León-Ramírez, C.G.; Abraham-Juárez, M.d.R.; Tlapal-Bolaños, B.; Olalde-Portugal, V.; Délano-Frier, J.P.; Martínez-Antonio, A.; Aguilar-Zárate, P. Neopestalotiopsis spp.: A threat to strawberry production and management. Horticulturae 2025, 11, 288. [Google Scholar] [CrossRef]
- Mudbhari, S.; Lofgren, L.; Appidi, M.R.; Vilgalys, R.; Hettich, R.L.; Abraham, P.E. Decoding the chemical language of Suillus fungi: Genome mining and untargeted metabolomics uncover terpene chemical diversity. mSystems 2024, 9, e0122523. [Google Scholar] [CrossRef] [PubMed]
- Fehrer, J.; Réblová, M.; Bambasová, V.; Vohník, M. The root-symbiotic Rhizoscyphus ericae aggregate and Hyaloscypha (Leotiomycetes) are congeneric: Phylogenetic and experimental evidence. Stud. Mycol. 2018, 92, 195–225. [Google Scholar] [CrossRef] [PubMed]
- Bizabani, C.; Fontenla, S.; Dames, J.F. Ericoid fungal inoculation of blueberry under commercial production in South Africa. Sci. Hortic. 2016, 209, 173–177. [Google Scholar] [CrossRef]
- Kurtzman, C.P. Blastobotrys americana sp. nov., Blastobotrys illinoisensis sp. nov., Blastobotrys malaysiensis sp. nov., Blastobotrys muscicola sp. nov., Blastobotrys peoriensis sp. nov. and Blastobotrys raffinosifermentans sp. nov., novel anamorphic yeast species. Int. J. Syst. Evol. Microbiol. 2007, 57, 1154–1162. [Google Scholar] [CrossRef]
- Parthibhan, S.; Ramasubbu, R. Mycorrhizal and endophytic fungal association in Paphiopedilum druryi (Bedd.) Stein—A strict endemic and critically endangered orchid of the Western Ghats. Ecol. Genet. Genom. 2020, 16, 100059. [Google Scholar]
- Miller, J.D.; Sumarah, M.W.; Adams, G.W. Effect of a rugulosin-producing endophyte in Picea glauca on Choristoneura fumiferana. J. Chem. Ecol. 2008, 34, 362–368. [Google Scholar] [CrossRef]
- McMullin, D.R.; Nguyen, H.D.T.; Daly, G.J.; Menard, B.S.; Miller, J.D. Detection of foliar endophytes and their metabolites in Picea and Pinus seedling needles. Fungal Ecol. 2018, 31, 1–8. [Google Scholar] [CrossRef]
- Massicotte, H.B.; Melville, L.H.; Peterson, R.L.; Molina, R. Biology of the ectomycorrhizal fungal genus, Rhizopogon: IV. Comparative morphology and anatomy of ectomycorrhizas synthesized between several Rhizopogon species on Ponderosa pine (Pinus ponderosa). N. Phytol. 1999, 142, 355–370. [Google Scholar] [CrossRef]
- Castellano, M.A.; Trappe, J.M.; Molina, R. Inoculation of container-grown Douglas-fir seedlings with basidiospores of Rhizopogon vinicolor and R. colossus: Effects of fertility and spore application rate. Can. J. For. Res. 1984, 15, 10–13. [Google Scholar] [CrossRef]
- Colgan, W.; Claridge, A.W. Mycorrhizal effectiveness of Rhizopogon spores recovered from faecal pellets of small forest-dwelling mammals. Mycol. Res. 2002, 106, 314–320. [Google Scholar] [CrossRef]
- Klich, M.A. Identification of Common Aspergillus Species; United States Agricultural Research Service, Southern Regional Research Center, Eds.; Centraalbureau voor Schimmelcultures: Utrecht, The Netherlands, 2002. [Google Scholar]
- Mousavi, B.; Hedayati, M.T.; Hedayati, N.; Ilkit, M.; Syedmousavi, S. Aspergillus species in indoor environments and their possible occupational and public health hazards. Curr. Med. Mycol. 2016, 2, 36–42. [Google Scholar] [CrossRef]
- Shi, C.-F.; Zhang, K.-H.; Chai, C.-Y.; Yan, Z.-L.; Hui, F.-L. Diversity of the genus Sugiyamaella and description of two new species from rotting wood in China. MycoKeys 2021, 77, 27–39. [Google Scholar] [CrossRef]
- Nasslahsen, B.; Prin, Y.; Ferhout, H.; Smouni, A.; Duponnois, R. Management of plant beneficial fungal endophytes to improve the performance of agroecological practices. J. Fungi 2022, 8, 1087. [Google Scholar] [CrossRef] [PubMed]
- Daniel, A.I.; Fadaka, A.O.; Gokul, A.; Bakare, O.O.; Aina, O.; Fisher, S.; Burt, A.F.; Mavumengwana, V.; Keyster, M.; Klein, A. Biofertilizer: The future of food security and food safety. Microorganisms 2022, 10, 1220. [Google Scholar] [CrossRef]

| Plant | Morphotype | Description |
|---|---|---|
| Pop. 1 Plant C cut root | I | Solid, white, fuzzy, circular formation with circles connecting in line, slightly raised |
| Pop. 1 Plant C cut root | II | Branching, transparent white fuzzy circular formation, with little to no center growth, very slightly raised, formed in connecting clusters |
| Pop. 1 Plant C cut root | III | Solid, white, fuzzy, uneven circular formation, raised |
| Pop. 1 Plant C uncut root | I | Solid, white, fuzzy, circular formation with circles connecting in line, slightly raised |
| Pop. 2 Plant A uncut root | IV | Solid, yellowish, fuzzy semicircular formation with translucent outer rim surround the circular formation, slight yellow indent center in circle formation |
| Morphotype | Species | Phylum | % Identity 1 | Region |
|---|---|---|---|---|
| MI | Penicillium rolfsii | Ascomycota | 99.4 | ITS |
| MII | Neopestalotiopsis sp. | Ascomycota | 96–99.7 | ITS |
| MIII | Neopestalotiopsis sp. | Ascomycota | 99.4–99.7 | ITS |
| MIV | Penicillium limosum | Ascomycota | 97.3 | 18s rRNA |
Disclaimer/Publisher’s Note: The statements, opinions and data contained in all publications are solely those of the individual author(s) and contributor(s) and not of MDPI and/or the editor(s). MDPI and/or the editor(s) disclaim responsibility for any injury to people or property resulting from any ideas, methods, instructions or products referred to in the content. |
© 2025 by the authors. Licensee MDPI, Basel, Switzerland. This article is an open access article distributed under the terms and conditions of the Creative Commons Attribution (CC BY) license (https://creativecommons.org/licenses/by/4.0/).
Share and Cite
Carnaggio, A.A.; Barthet, M.M. It’s a Question at the ‘Root’ of the Problem: Fungal Associations of Dionaea muscipula (Venus’ Flytrap) Roots in Its Native Habitat. Microorganisms 2025, 13, 2269. https://doi.org/10.3390/microorganisms13102269
Carnaggio AA, Barthet MM. It’s a Question at the ‘Root’ of the Problem: Fungal Associations of Dionaea muscipula (Venus’ Flytrap) Roots in Its Native Habitat. Microorganisms. 2025; 13(10):2269. https://doi.org/10.3390/microorganisms13102269
Chicago/Turabian StyleCarnaggio, Anna A., and Michelle M. Barthet. 2025. "It’s a Question at the ‘Root’ of the Problem: Fungal Associations of Dionaea muscipula (Venus’ Flytrap) Roots in Its Native Habitat" Microorganisms 13, no. 10: 2269. https://doi.org/10.3390/microorganisms13102269
APA StyleCarnaggio, A. A., & Barthet, M. M. (2025). It’s a Question at the ‘Root’ of the Problem: Fungal Associations of Dionaea muscipula (Venus’ Flytrap) Roots in Its Native Habitat. Microorganisms, 13(10), 2269. https://doi.org/10.3390/microorganisms13102269

